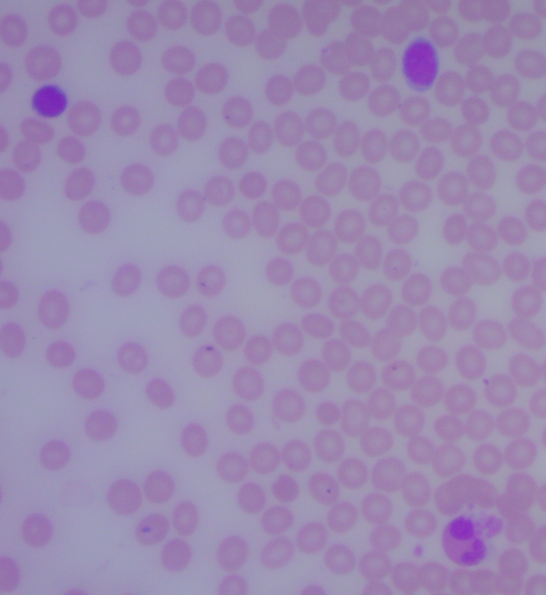
瑞氏-吉姆薩圖.png 瑞氏-吉姆薩圖.png

1. 美國進口原材料,保證品質
2. 細胞形態完整,不同細胞染色特征典型,易于區別
3. 適用于血細胞涂片、骨髓涂片、陰道分泌物(婦科白帶)涂片、脫落細胞涂片的染色,對臨床檢驗和臨床病理學起輔助診斷作用
【產品特點】
1、美國進口原材料,保證品質
2、細胞形態完整,不同細胞染色特征典型,易于區別
【適用范圍】
適用于血細胞涂片、骨髓涂片、陰道分泌物(婦科白帶)涂片、脫落細胞涂片的染色,對臨床檢驗和臨床病理學起輔助診斷作用
【儲存條件】常溫密封避光保存,用后蓋緊瓶蓋以防染色液揮發
【有效期】 一年
【檢驗原理】
瑞氏-吉姆薩染色液是利用Romanowsky Stain技術原理改良而成的。細胞的著色過程是染料透入被染物并存留其內部的一種過程,此過程既有物理吸附作用,又有化學親和作用。瑞氏染料是由酸性染料曙紅(Eosin)和堿性染料亞甲藍(Methylene Blue)組成的復合染料,吉姆薩染料由堿性天青Ⅱ和酸性曙紅組合而成。各種細胞及細胞的各種成分由于其化學性質不同,對瑞氏-吉姆薩染色液中的酸性染料(曙紅)和堿性染料(亞甲藍、天青Ⅱ)的親和力也不一樣。因此,標本涂片經瑞氏-吉姆薩染色液染色后,相應各類細胞呈現不同的顏色,從而達到辨別其形態特征的目的
【實際染色效果】